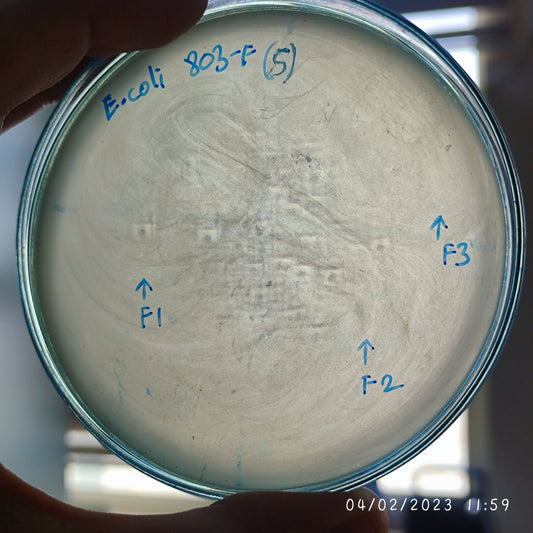
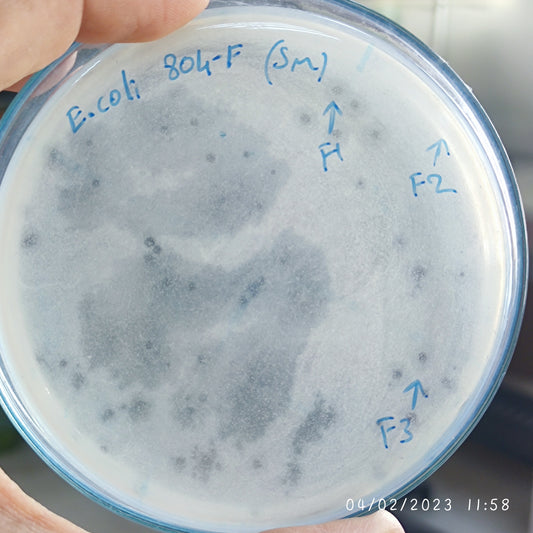
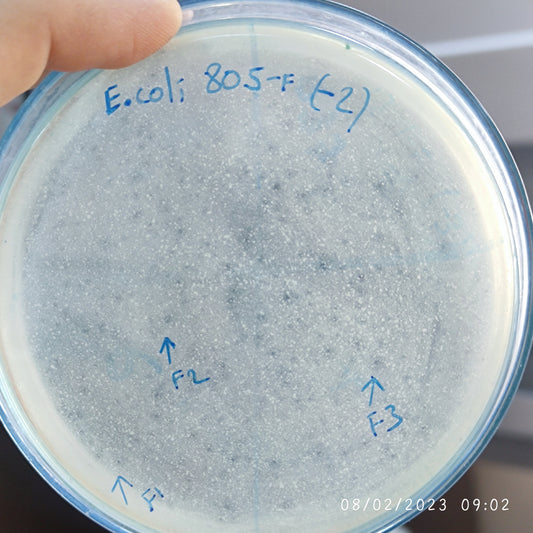
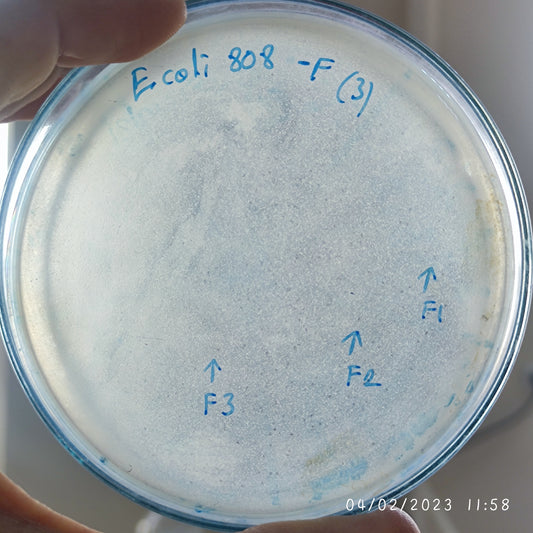
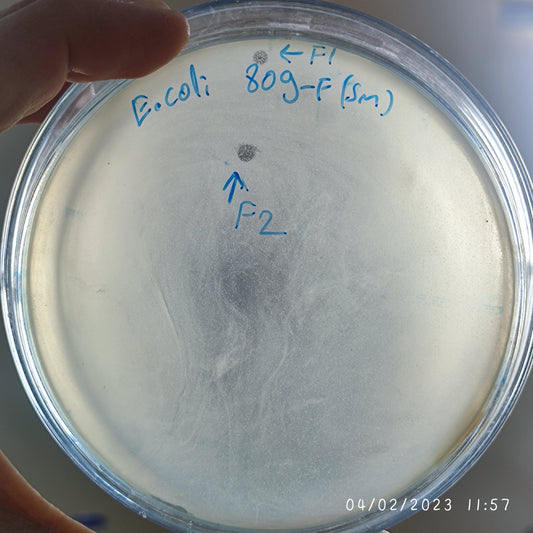
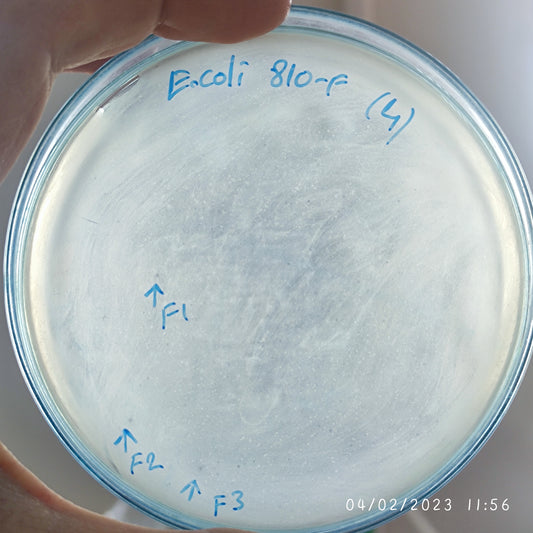
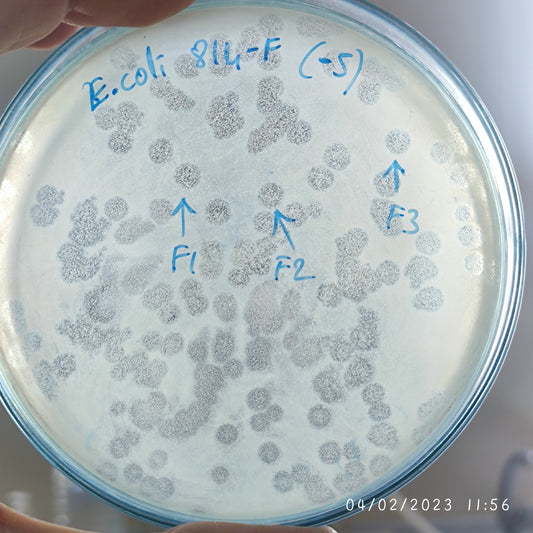
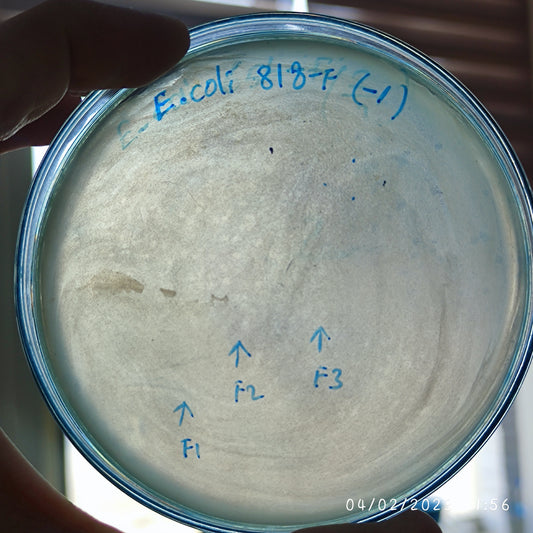
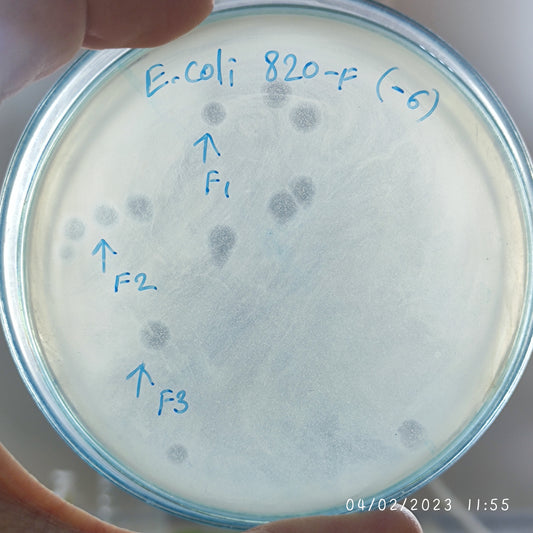
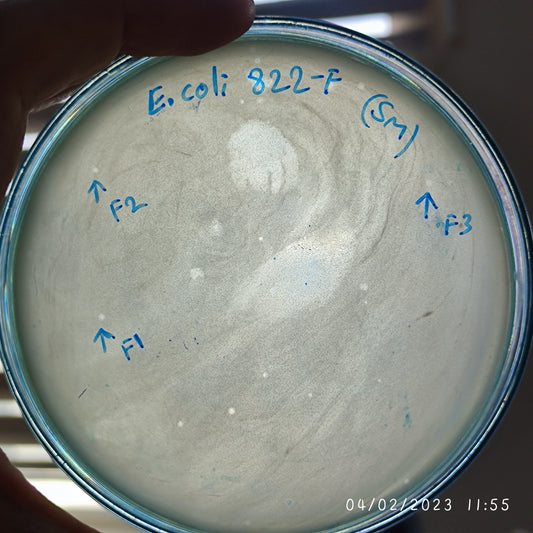
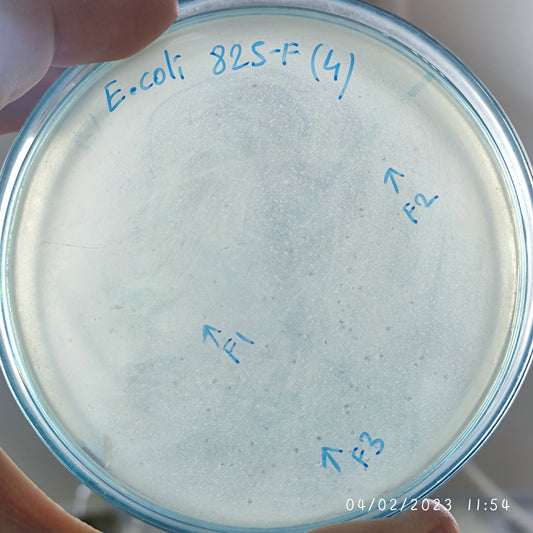
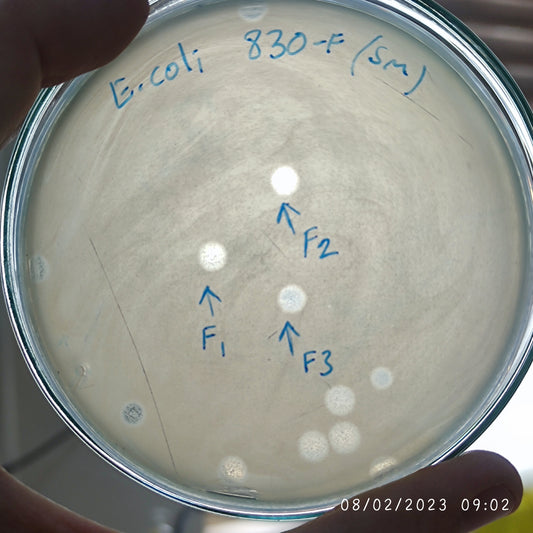
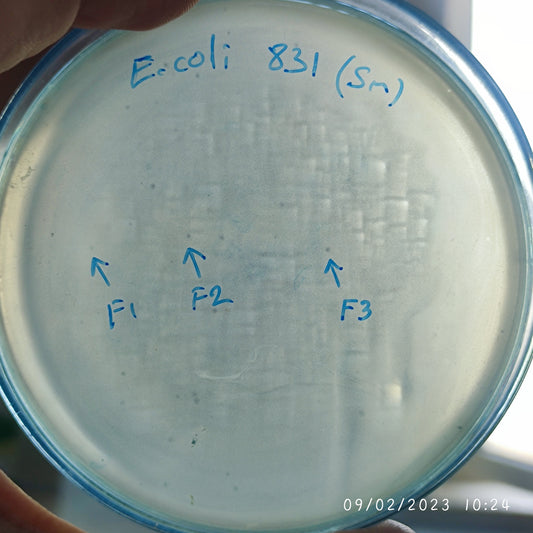
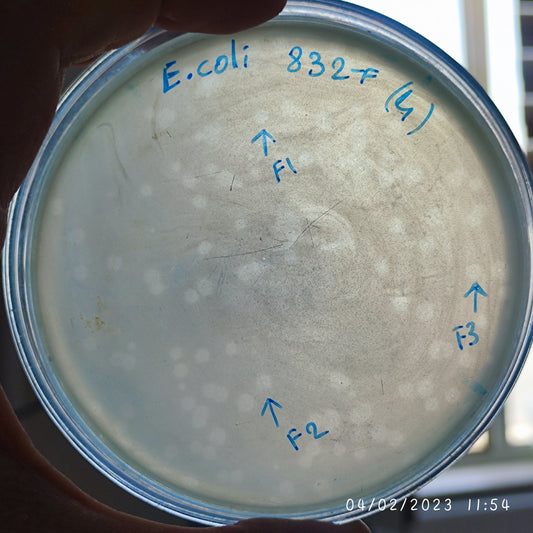

-
Escherichia coli bacteriophage 100803F
Regular price $650.00 USDRegular priceUnit price per -
Escherichia coli bacteriophage 100804F
Regular price $600.00 USDRegular priceUnit price per -
Escherichia coli bacteriophage 100805F
Regular price $750.00 USDRegular priceUnit price per -
Escherichia coli bacteriophage 100808F
Regular price $750.00 USDRegular priceUnit price per -
Escherichia coli bacteriophage 100809F
Regular price $750.00 USDRegular priceUnit price per -
Escherichia coli bacteriophage 100810F
Regular price $700.00 USDRegular priceUnit price per -
Escherichia coli bacteriophage 100811F
Regular price $700.00 USDRegular priceUnit price per -
Escherichia coli bacteriophage 100814F
Regular price $800.00 USDRegular priceUnit price per -
Escherichia coli bacteriophage 100818F
Regular price $500.00 USDRegular priceUnit price per -
Escherichia coli bacteriophage 100820F
Regular price $750.00 USDRegular priceUnit price per -
Escherichia coli bacteriophage 100822F
Regular price $750.00 USDRegular priceUnit price per -
Escherichia coli bacteriophage 100825F
Regular price $750.00 USDRegular priceUnit price per -
Escherichia coli bacteriophage 100828F
Regular price $700.00 USDRegular priceUnit price per -
Escherichia coli bacteriophage 100830F
Regular price $750.00 USDRegular priceUnit price per -
Escherichia coli bacteriophage 100831F
Regular price $500.00 USDRegular priceUnit price per -
Escherichia coli bacteriophage 100832F
Regular price $650.00 USDRegular priceUnit price per